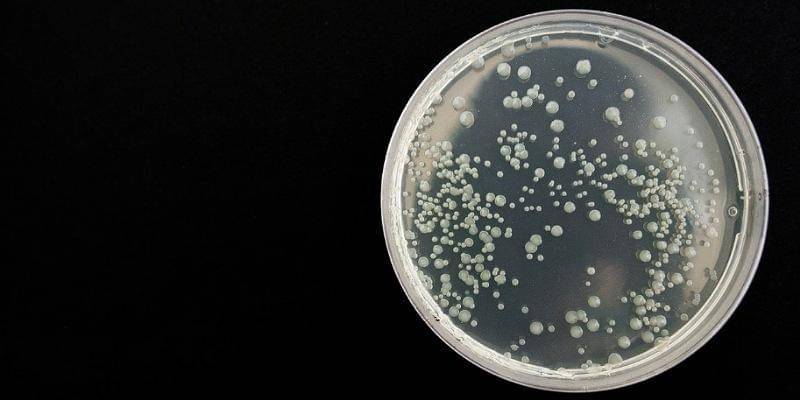
Pixabay/nadya_il

Dimana Posisi Manusia dalam Rantai Makanan?

Dalam rangka bertahan hidup, makhluk hidup menjalankan apa yang disebut dengan rantai makanan. Rantai makanan adalah proses makhluk hidup memakan dan dimakan secara alami.
Rantai makanan bukan hanya melibatkan hewan dan tumbuhan, melainkan juga melibatkan manusia. Lantas, di mana sih posisi manusia dalam rantai makanan?
Berikut ini Popmama.com merangkum penjelasannya.
1. Apa itu rantai makanan?

Rantai makanan adalah peristiwa makan dan dimakan antara sesama makhluk hidup, seperti yang dilansir dari Kemendikbud.
Peristiwa ini melibatkan beragam peran, yaitu produsen, konsumen, dan pengurai.
Dalam setiap tingkatan rantai makanan memiliki ekosistem yang disebut dengan tingkat trofik, yaitu urutan posisi pemanfaatan pakan atau material.
2. Siapakah yang menempati tingkat trofik pertama dalam rantai makanan?

Dalam rantai makanan, produsen menempati tingkat trofik yang pertama. Produsen ini adalah organisme yang memproduksi makanan mereka sendiri atau disebut dengan autotrof.
Organisme autotrof biasanya adalah tumbuhan atau organisme yang memiliki satu sel.
3. Siapakah yang menempati tingkat trofik kedua, ketiga, dan keempat dalam rantai makanan?

Setelah produsen yang menempati tingkat trofik pertama, tingkat trofik kedua dan selanjutnya dalam rantai makanan adalah organisme yang langsung memakan produsen. Pada tingkat trofik kedua ini konsumen juga disebut dengan konsumen primer atau herbivora.
Contoh konsumen tingkat trofik kedua adalah ayam, rusa, dan burung.
Pada tingkatan trofik ketiga adalah konsumen sekunder yang memakan hewan herbivora, biasanya adalah hewan pemakan daging (karnivora).
Kemudian di tingkatan trofik keempat adalah konsumen tersier yang memakan konsumen sekunder.
Namun, perlu diketahui bahwa tingkatan ini tidak hanya berhenti pada tingkat trofik keempat. Ada kemungkinan sebuah rantai makanan memiliki lebih banyak tingkat konsumen.
Organisme yang menduduki tingkat tropik tertinggi disebut dengan konsumen puncak.
4. Posisi pengurai dalam rantai makanan
Pengurai, atau yang juga disebut dengan detritivora adalah bagian paling akhir dari rantai makanan. Pengurai merupakan organisme yang memakan sisa-sisa tumbuhan dan hewan yang sudah mati.
Pengurai punya tugas untuk menyelesaikan siklus kehidupan, mengurai nutrisi ke tanah yang digunakan oleh produsen. Dari proses inilah, rantai makanan kembali terbentuk.
Contoh pengurai adalah kumbang kotoran yang memakan kotoran hewan, atau jamur dan bakteri yang mengurai sampah-sampah organik.
5. Di mana posisi manusia dalam rantai makanan?

Untuk bertahan hidup, manusia tidak bisa melakukannya sendiri. Manusia membutuhkan tanaman dan hewan.
Manusia mengolah tumbuhan sebagai sayur, buah, dan kacang-kacangan yang bernutrisi untuk tubuh. Tak hanya itu, manusia juga mengolah daging hewan, telur, dan susu sebagai sumber lemak dan protein.
Oleh karena itulah, manusia menempati peran sebagai konsumen dalam rantai makanan.
6. Siapa yang berada di puncak rantai makanan?

Ternyata manusia tidaklah menempati posisi puncak dalam rantai makanan. Yang berada di puncak dalam rantai makanan adalah predator.
Predator ini tidak dimangsa oleh hewan lain di lingkungannya. Manusia punya kemungkinan dimangsa oleh predator berupa hewan-hewan besar dan buas jika mengalami celaka.
Contoh predator adalah komodo, singa, hiu, buaya, atau pun macan.
Meskipun tampak ganas, ternyata predator adalah spesies kunci yang berperan untuk mempertahankan dan mengubah keseimbangan ekosistem sehingga keberadaannya tetap dibutuhkan.
Demikianlah informasi seputar rantai makanan dan di mana posisi manusia dalam rantai makanan. Semoga informasi ini dapat menambah wawasan ya.



















